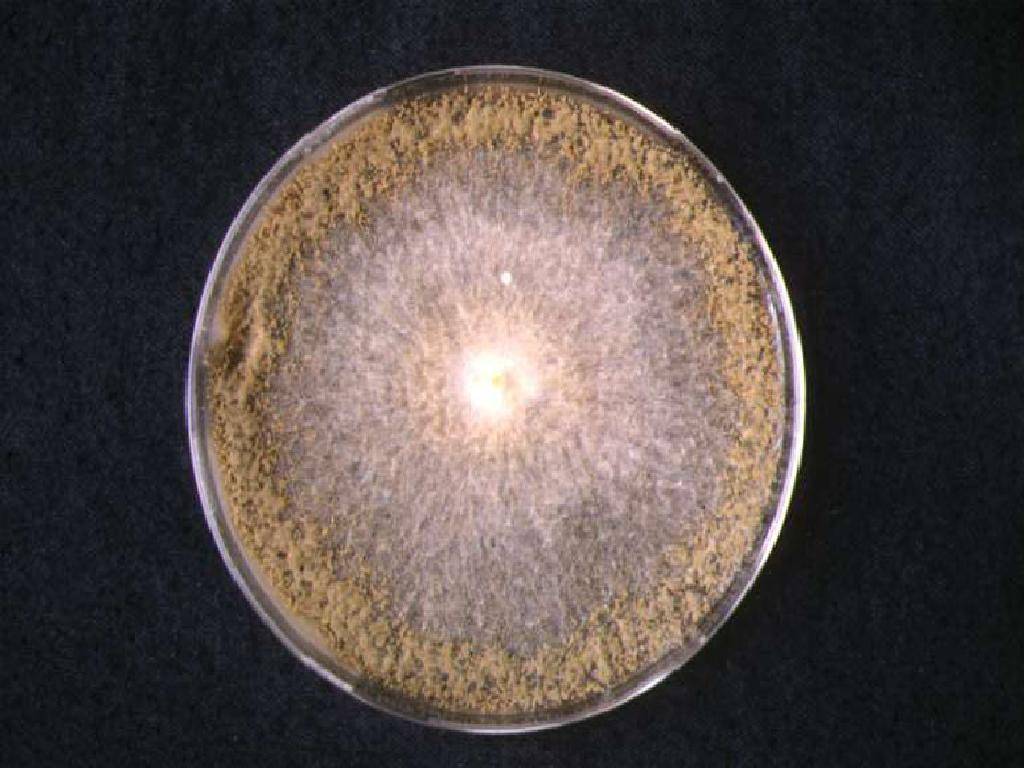

Защита от плесени
В местах образования повышенной влажности (ванная комната, кухня, подвал) регулярное проветривание сможет улучшить ситуацию. Но если этого окажется не достаточно, стоит установить осушитель воздуха и провести замену или ремонт системы вентиляции. Установление принудительной вентиляции обеспечивающей постоянную циркуляцию воздуха может стать решением проблемы с возникновением споров грибка.
Зная, в каких местах в доме существуют условия для роста плесени стоит регулярно делать их осмотр. Это поможет своевременно обнаружить угрозу и быстро устранить ее на начальном этапе.
Если так получилось, что плесень значительно распространилась по зданию, справиться своими силами с ней не получится, как впрочем, и при локальном повреждении. В таком случае наши специалисты помогут определить причины ее возникновения и устранить их. Только после этого проводится комплекс мер по качественному удалению плесневого грибка специальным оборудованием.
Появление и распространение плесени – неприятное и частое явление. Нет смысла поддаваться панике и совершать опрометчивые поступки, столкнувшись с ней. Обладание знаниями о признаках заражения плесенью, причинах ее появления и способах предотвращения позволит быстро принять меры, избавляющие от нее раз и навсегда, сохранив при этом хорошее самочувствие и имущество.
Готовимся к борьбе с плесенью
Прежде чем приступить к непосредственному удалению колонии грибков, стоит тщательно подготовиться к данной процедуре. Это поможет избавиться от чёрной плесени с наибольшей эффективностью.
- Определите местоположение вредоносных микроорганизмов: принюхайтесь, рассмотрите все поверхности, особенно скрытые от глаз места.
Возьмите полиэтиленовую плёнку и перекройте ей вентиляцию. Это поможет предотвратить распространение выделяемых плесенью спор.
- Наденьте маску или респиратор, защитите глаза очками, а руки – хозяйственными перчатками.
Приобретите специальную щётку с металлической щетиной – она отлично удаляет плесень.
- Будьте готовы, что некоторые поражённые участки придётся заменить. Гиспокартон, обои после механического воздействия на них потеряют свой прежний вид.
В поисках плесени
Плесень и грязь на окне: плесень процветает в конденсате, который собирается на оконных рамах. Stachybotrys довольно легко идентифицировать. Это так называемая черная плесень вполне оправдывает свое название – она действительно зеленовато-черная. Споры питаются целлюлозой, поэтому вы часто найдете плесень, растущей на дереве или гипсокартонной бумаге. Кроме целлюлозы, stachybotrys, как и все формы, нуждается в увлажнении. Она часто растет во влажных областях, таких как подвалы, темные шкафы, ванные комнаты и плохо проветриваемые углы.
Плесень может не принадлежать к виду stachybotrys, это может быть любой из нескольких других видов, которые обычно растут в домах. Многие из этих видов также являются аллергенами, а некоторые, как alternaria infectoria — самый распространенный вид — выглядят очень похожими. Alternaria, наиболее вероятно, ответственен за изменение цвета ваших окон. Он может вызвать астмоподобные симптомы и быстро растет. Другие аллергенные виды включают:
- Cladosporium herbarum в портьерах, текстиле и других тканях;
- Mucor racemosus при вентиляции и кондиционировании воздуха;
- Aspergillus, который может производить канцерогенные микотоксины.
Поскольку формы могут выглядеть очень похожими, их довольно трудно идентифицировать, и центры по контролю и профилактике заболеваний рекомендуют вам даже не пытаться сделать это самостоятельно. Пригласите специалистов, которые возьмут пробу плесени для анализа в лаборатории, только так вы сможете найти эффективный метод по борьбе с этим отравителем вашей жизни.
Кое-что о плесени. Польза и вред плесневого грибка
Как известно, плесень – это грибок, его споры находятся в воздухе в подвешенном состоянии. При попадании спор на благоприятную для размножения поверхность (например, на сырую стену) плесень начинает очень быстро расти – только за одни сутки колония плесневых грибов может увеличиться в 9 раз.

Наверное, многие знают, что первый антибиотик, который стали применять в медицине, – это пенициллин. Он был получен из плесневого гриба пенициллиума (отсюда получилось название препарата). Открытие антибактериальных свойств плесени помогло спасти тысячи человеческих жизней.
Благодаря своей способности подавлять жизнедеятельность различных микробов, плесень нашла свое применение не только в медицине, но и в пищевой промышленности. Применение некоторых видов плесневого грибка для приготовления различной колбасной продукции, а также элитных сортов сыра позволяет значительно продлить срок хранения конечного продукта. Широко известный сыр с плесенью ценят за особый тонкий вкус и аромат. Главное, при изготовлении таких продуктов питания нужно строго следить за технологией, иначе на выходе можно получить товар с колонией недоброкачественной плесени.
Но далеко не всегда плесень полезна. Чаще всего она может значительно навредить здоровью. Из-за того, что споры плесени легко проникают в легкие человека, она может вызвать такие заболевания органов дыхания, как астма и хронический бронхит. Оседая на коже и слизистых тканях, плесневый грибок начинает раздражать поверхность, может появиться сильный зуд, вплоть до аллергических реакций.
Плесень может вызвать и более серьезные заболевания, способные привести к летальному исходу. Существуют доказательства того, что ее споры могут стать причиной лейкоза. К раку печени может привести очень ядовитая желтая плесень, способная выделять афлатоксин, со временем накапливающийся в организме. Данный вид плесени можно встретить на продуктах, богатых белком.
Плесневые грибы, которые появляются на поверхностях слишком влажных помещений, выделяют микотоксины. Они крайне негативно сказываются на общем состоянии человека – появляются головные боли, быстрая утомляемость, расстройство пищеварения, снижается иммунитет. В случае серьезного нарушения иммунной системы, плесень может начать прорастать в организме человека. Это может привести как к аллергическому заболеванию, так и к серьезному поражению легких. В первую очередь от плесени могут пострадать дети, беременные женщины и люди, у которых снижен иммунитет в результате различных заболеваний.
Не только человек страдает от присутствия плесени. Она поражает и приводит в негодность самые различные поверхности – бетонные, кирпичные, деревянные, резиновые, пластиковые, оштукатуренные.
Полностью избавиться от присутствия спор плесени в воздухе невозможно. Самое главное – создать им непригодные для размножения условия.
Токсичные виды плесени
Aspergillus flavus
 Производит микотоксин под названием афлатоксин B, канцероген и самое токсичное природное соединение рака печени на планете.Протестировано и хранится на складе для использования в биологической войне.Вторая ведущая причина аспергиллеза (разрастание грибов, которое является частой причиной смерти пациентов с ослабленной иммунной системой при таких заболеваниях, как ВИЧ и некоторые виды рака).Симптомы его воздействия включают хронический синусит и кератит, инфекции кожи и ран, а также остеомиелит после травмы или вакцинации.
Производит микотоксин под названием афлатоксин B, канцероген и самое токсичное природное соединение рака печени на планете.Протестировано и хранится на складе для использования в биологической войне.Вторая ведущая причина аспергиллеза (разрастание грибов, которое является частой причиной смерти пациентов с ослабленной иммунной системой при таких заболеваниях, как ВИЧ и некоторые виды рака).Симптомы его воздействия включают хронический синусит и кератит, инфекции кожи и ран, а также остеомиелит после травмы или вакцинации.
Aspergillus fumigatus
 Производит глиотоксины, которые подавляют активность иммунной системы и влияют на мозг.Часто встречается в жилых домах и коммерческих зданиях.Основная причина аспергиллеза.
Производит глиотоксины, которые подавляют активность иммунной системы и влияют на мозг.Часто встречается в жилых домах и коммерческих зданиях.Основная причина аспергиллеза.
Aspergillus ochraceus
 Вырабатывает охратоксин А, который подавляет синтез белка и клеточное дыхание, а также стимулирует повреждение клеточных мембран свободными радикалами.Охратоксин А канцерогенен, токсичен для почек и печени, вызывает врожденные дефекты и подавляет иммунную систему.
Вырабатывает охратоксин А, который подавляет синтез белка и клеточное дыхание, а также стимулирует повреждение клеточных мембран свободными радикалами.Охратоксин А канцерогенен, токсичен для почек и печени, вызывает врожденные дефекты и подавляет иммунную систему.
Aspergillus niger
 Одна из наиболее распространенных форм плесени, обнаруживаемая в продуктах питания, поражающая почву, семена, растения, орехи и сухофрукты.Как и Aspergillus ochraceus, он продуцирует охратоксин А.
Одна из наиболее распространенных форм плесени, обнаруживаемая в продуктах питания, поражающая почву, семена, растения, орехи и сухофрукты.Как и Aspergillus ochraceus, он продуцирует охратоксин А.
Aspergillus versicolor
 Одна из форм, наиболее часто встречающихся в затопленных зданиях.Производит микотоксин под названием стеригматоцистин, который классифицируется как возможный канцероген для человека, связанный с раком легких и печени у животных.
Одна из форм, наиболее часто встречающихся в затопленных зданиях.Производит микотоксин под названием стеригматоцистин, который классифицируется как возможный канцероген для человека, связанный с раком легких и печени у животных.
Chaetomium globosum
Встречается в зданиях, которые были затоплены водой, с высокой влажностью или влажностью.Производит микотоксины, называемые хетоглобозином А и С, которые очень смертельны для клеток (подавляют их деление и подвижность).
Встречается в зданиях, которые были затоплены водой, с высокой влажностью или влажностью.Производит микотоксины, называемые хетоглобозином А и С, которые очень смертельны для клеток (подавляют их деление и подвижность).
Споры кладоспориума
Более 40 видов можно найти в почве и растительном материале, а споры, разносимые ветром, распространены на открытом воздухе в большом количестве, их количество достигает 50 000 на 1 м3 воздуха.Споры также часто встречаются на подверженных воздействию влаги строительных материалах, таких как системы гипсокартона, напольные покрытия, акриловые окрашенные поверхности, дерево, обои, системы отопления/вентиляции/кондиционирования воздуха и изоляционные материалы.Основной источник переносимых по воздуху аллергенов.
Фузариум
 Поражает зерновые культуры, такие как пшеница, ячмень и овес.Производит микотоксины, называемые простыми трихотеценами (включая Т-2, дезоксиниваленол), фумонизин и зеараленон.Т-2 может подавлять иммунную систему, тошноту и рвоту; это также известный боевой химический агент.
Поражает зерновые культуры, такие как пшеница, ячмень и овес.Производит микотоксины, называемые простыми трихотеценами (включая Т-2, дезоксиниваленол), фумонизин и зеараленон.Т-2 может подавлять иммунную систему, тошноту и рвоту; это также известный боевой химический агент.
Penicilium verrucosum
 Вырабатывает охратоксин А
Вырабатывает охратоксин А
Stachybotrys chartarum
Черная плесень, чаще всего связанная с токсичностью, продуцирует микотоксины, в т.ч. трихотецены.Споры легкие и плавают в воздухе, прилипая к частицам пыли.Плесень легко вдыхается и оказывает прямое воздействие на мозг и остальное тело, нарушая синтез белка.Симптомы воздействия включают потерю мышечного контроля, головокружение, тошноту, рвоту, жжение, воспаление кожи, диарею, озноб, лихорадку и умственный туман.
Валлемия себи
 Производит такие соединения, как валлеминол, валлеминон и валлемия A и C.
Производит такие соединения, как валлеминол, валлеминон и валлемия A и C.
Вызывает неприятное послевкусие и комкование молотых специй; обычно содержится в продуктах с высоким содержанием сахара, пирожных, сгущенном молоке, крупах, хлебе, молотом рисе и муке, а также в осевшей домашней пыли.
Хроническое воздействие вызывает аллергию и воспаление. Кроме того, он увеличивает риск ринита и синусита, а также бронхита и респираторных инфекций.
Как можно избежать распространения плесневого грибка в ванных комнатах
Самое благоприятное место для развития плесени – ванная комната. Здесь практически всегда повышенная влажность, прохлада, отсутствие сквозняков и солнечного света. Не всегда плесень можно разглядеть сразу, а вот запах от нее распространяется довольно быстро. Если вы почуяли, что в вашей ванной комнате воздух стал затхлым, возможно, плесень уже где-то осела и начала размножаться. Чтобы этого избежать, необходимо принять ряд профилактических мер:
Самое главное условие для ванной комнаты – обеспечить ей приток свежего воздуха. Это поможет поддерживать поверхности максимально сухими. Чтобы в ванной не застаивался влажный воздух, по возможности держите дверь открытой. Проверьте работу вентиляционного отверстия. Периодически вентканалы необходимо прочищать (для этого следует обратиться в ЖЭУ). Оптимально будет оборудовать отдушину системой принудительной вентиляции.
- Часто в ванной влажность достигает 90%. Именно такой уровень самый благоприятный для развития плесени. Чтобы максимально осушить воздух, необходимо после каждого принятия ванны вытирать поверхности, на которых скопился конденсат – кафель, зеркала, металлические трубы. Кроме этих мер, проследите за исправностью кранов – они не должны подтекать.
- Очень часто встречается такая планировка квартир, где стена ванной комнаты является смежной с подъездной. В этом случае, а также при угловом расположении квартиры, стены стоит дополнительно утеплить. Так можно не только уменьшить количество конденсата, но и сохранить в ванной теплый воздух.
- Плесень очень любит поселяться в щелях, где постоянно скапливается сырость. Поэтому в ванной комнате все стены должны быть максимально ровными и гладкими. Если штукатурка или кафельная плитка потрескались, значит необходимо сделать ремонт.
- Очень редко можно встретить квартиры, в ванных комнатах которых есть окно. А ведь именно благодаря ультрафиолетовому излучению можно избежать распространения различных микроорганизмов, в том числе и плесени. Если у вас есть возможность сделать окно в ванной комнате, обязательно ею воспользуйтесь.
- Если вариант с окном невозможен, то для борьбы с плесенью, а также и в целях профилактики периодически включайте в ванной комнате лампу с ультрафиолетовым излучением. Поможет справиться с плесенью и бытовой ионизатор воздуха. Главное, чтобы во время обработки помещения в нем не было людей.
- Периодически обрабатывайте поверхности, особо подверженные появлению плесени (например, в углах ванны), специальными противогрибковыми препаратами.
Какие бывают виды и чем они опасны?
Еще один факт, который необходимо знать, чтобы вывести плесень на стенах — ее вид. Наиболее распространенными считаются:
- Черная плесень. Пораженные участки покрываются темными спорами разных размеров: именно такие чаще всего встречаются в жилых помещениях. Грибок Aspergillius Niger питается органикой и прекрасно себя чувствует при высокой влажности: может расти на штукатурке, кирпиче, бетоне, обоях, даже на пластиковых панелях.
- Зеленая плесень. Penicillium любят не только хлеб и другие продукты питания, часто их споры можно встретить на оштукатуренных, окрашенных поверхностях.
- Синяя плесень. Наиболее опасна для натурального дерева и стружечных материалов (ДСП, ЛДСП, ДВП). Чаще всего встречается в деревянных домах.
- Домовой гриб. Еще один вредитель срубов — отличается от предыдущих видов не только внешне, но и по воздействию. Serpula lacrymans агрессивен — разрушая древесину изнутри способен разрушить и само строение.
Если вы считаете, что удаление плесени может подождать — спешим переубедить. Вывести плесень со стен в квартире необходимо не только для возвращения эстетичного внешнего вида, но и заботы о здоровье домочадцев. Ведь постоянное вдыхание микроорганизмов приводит к множеству неприятных заболеваний – аллергия или даже астма.
Причины, по которым в доме появляется плесень
Самая основная причина появления в доме плесени – повышенная влажность. В свою очередь влажность может быть связана с некоторыми особенностями микроклимата в вашем регионе
Обратите внимание, нет ли промерзаний в зоне окна или углов комнаты, а также не образуется ли в этих зонах конденсат. Также если обои поменяли цвет только на одном участке стены, следует провести проверку влажности помещения
 ФОТО: diy.obi.ruПри отсутствии вентиляции в квартире не обеспечивается циркуляция воздуха, из-за чего плесень быстро нарастает на стенах и в углах комнаты
ФОТО: diy.obi.ruПри отсутствии вентиляции в квартире не обеспечивается циркуляция воздуха, из-за чего плесень быстро нарастает на стенах и в углах комнаты
Три главные причины образования чёрной плесени:
- плохая вентиляция;
- повышенная влажность и частые протечки на кухне и в ванной;
- плохой, неравномерный прогрев жилого помещения.
Особое внимание следует обратить на ванную комнату: там плесень появляется на плиточных швах, на раковине и под ванной. Главная причина этого – плохая вытяжка в «мокрой зоне»
 ФОТО: ogipse.ruЕсли в комнате соблюдается нормальная влажность, но вы обнаружили плесень на одной стене – проверьте трубы: возможно, произошла протечка воды
ФОТО: ogipse.ruЕсли в комнате соблюдается нормальная влажность, но вы обнаружили плесень на одной стене – проверьте трубы: возможно, произошла протечка воды
Как избавиться от чёрной плесени
Уничтожение плесени – задача не из самых простых. А если речь идёт о чёрной, то даже не стоит терять время и деньги на самостоятельную борьбу. Победителем вы из неё точно не выйдете. Это работа для профессионалов.
Обратившись в сертифицированную компанию, Городская дезстанция в Санкт-Петербурге, будьте готовы, что к вам может приехать целая бригада специалистов. Выезд осуществляется в любое удобное для заказчика время, в том числе ночью и очень срочно. Каким бы незначительным не казалась проблема чёрной плесени – не стоит недооценивать своего врага.
Исключительно на месте специалисты оценивают масштаб поражения и определяют тип плесневых грибов, с которыми они имеют дело. После этого, осуществляется подбор дезинфицирующего средства и его оптимальной концентрации, достаточной для уничтожения плесени с первого раза. В случае, если проблема серьёзнее, чем кажется, производится «купирование» колонии и работа производится в несколько этапов.
Учитывайте, никакие хлорсодержащие средства и доступная в свободной продаже бытовая и прочая химия, даже если на ней указано, что она способна убивать чёрную плесень – на самом деле не работает. Максимум – вы просто её обесцветите, но проблему не решите. Грибок проникает внутрь материала. А специализированные составы, которые действительно способны убивать споры чёрной плесени и воздействовать на активные колонии – в продаже недоступны. Они относятся к 4 классу малоопасных веществ, которые безопасны для людей и домашних животных
Тем не менее, при работе с ними, соблюдение мер предосторожности строго обязательно как для специалиста, так и для владельца помещения, если он решил присутствовать при обработке. А вот любая бытовая химия – гораздо токсичнее
Поэтому не стоит применять её безрассудно, чтобы ещё больше не навредить своему здоровью.
Когда промышленные и народные средства не помогают
Иногда случается так, что плесень прочно въелась в затирку, которая находится между кафельной плиткой. Если никакие методы борьбы не помогли от нее избавиться, придется полностью очистить пространство между швами с помощью специальных инструментов. После этого все углубления необходимо обезжирить (например, «Уайт спиртом»), просушить и нанести новый герметик. Можно взять такой, который в будущем убережет от повторного появления плесени.

Когда плесень прочно въелась в поверхность стен и даже после тщательной уборки появляется снова, придется прибегнуть к такому радикальному методу, как ремонт. Со стен, потолка и пола необходимо снять все старые покрытия. Затем все поверхности необходимо тщательно просушить. Если у вас нет специального строительного фена, на это может уйти много времени. Перед тем, как заняться новой отделкой стен, их обязательно следует обработать специальными средствами от плесени
Не забывайте о том, что они очень токсичны и требуют особой осторожности в работе
Борьба с плесенью – дело не всегда простое. Поэтому старайтесь не допускать ее возникновения, а при первых же признаках появления плесневого грибка – сразу же принимайте меры.
https://youtube.com/watch?v=qqjHqT7l4fI
Признаки появления грибка
О том, что появилась плесень в доме, сначала намекнет навязчивый запах сырости. Позже отчетливо проявятся другие признаки:
- изменение цвета поверхностей;
- шелушение оштукатуренных стен;
- образование черных, серых или белых пятен и точек;
- появление налета, напоминающего корки, пленку, порошок;
- деформация структуры материала – дерево начнет сморщиваться, растрескиваться, краска – расслаиваться.
Определив источник неприятного запаха, приступают к работе. Чтобы вывести грибок со стен, потолка или пола, требуется запастись терпением и познакомиться с методами избавления.

Заплесневевшие стены темнеют
Что такое домашняя плесень. Ее основные виды
Подобный налет немного отличается от пищевого не только структурой, но и характером распространения. Такой грибок может находиться везде, ведь плесени совершенно все равно на какой поверхности существовать. Трудность в выведении плесени заключается в том, что у нее есть свойство проникать не только на поверхность тканей, но и внутрь их. Таким образом, процесс выведения значительно усложняется.

Существует определенная классификация домашней плесени, которая очень часто основывается на ее цвете. Встречаются следующие виды:
- Белая плесень. Возникает в основном в цветочных горшках, а именно в земле. Также ее можно наблюдать на деревянных предметах мебели, но этот случай встречается реже.
- Черная плесень. Самый распространенный вид грибка, поскольку распространяется быстрее всего. Находится в основном на поверхностях и покрытиях в помещении: обои, плитка или кафель в ванной комнате, стены, обычный потолок и т.д. Вывести очень трудно.
- Зеленая плесень. Воздействует в основном на продукты питания: на предметах мебели ее почти не увидишь, только в самых редких случаях.
- Синяя плесень. Распространяется на окна, особенно на деревянные оконные рамы. Также этот вид характерен для паркетных полов и различной мебели, причем не только деревянной.
Можно встретить налет и другого цвета, но данные категории увидеть наиболее вероятно. К тому же, чтобы бороться с плесенью, нужно обязательно знать характеристику того или иного вида. Так можно выбрать более эффективный способ устранения проблемы.
Как осуществить механическое очищение поверхности
Чтобы правильно убрать плесень, сначала необходимо осуществить механическую очистку и не повредить поверхность. Рассмотрим несколько очень важных и полезных рекомендаций:
Все видимые поражения должны быть удалены
С поверхности обязательно нужно удалить весь имеющийся грибок при помощи губки или жесткой щетки.
Чтобы споры не распространялись по воздуху в процессе очистки, важно постоянно поддерживать поверхность влажной – смачивайте ее водой.
Плесень на обоях нельзя запускать. Если грибок только появился, то его еще можно вывести
Но при более глубоком проникновении зачищать поверхность придется чуть ли не до штукатурки, а значит и полностью менять обои.
Понадобится скребок. Если использовалась известь, то необходимо удалить плесень со всех стыков плитки или другой поверхности специальным скребком. Это поможет вывести источник заражения.
Плесень в ванне. Она появляется в основном в швах между стенами, сантехникой или пространством в кафеле. Поэтому нужно очистить эти участки и тщательно загерметизировать.

Эти простые советы помогут более грамотно зачистить проблемные участки в помещении своими руками. Главное, действовать строго по инструкции, и тогда плесень точно больше не будет страшна вашему дому.
Техника безопасности
При работе с химическими средствами очень важно соблюдать технику безопасности. Потому что опасные пары могут сильно навредить организму и дыхательным путям
Ядовитые составы разъедают кожу рук, если не использовать перчатки. Помните о следующих не менее важных моментах:
Проветривать комнату. Чтобы не надышаться парами, а также предотвратить концентрацию спор в воздухе, нужно обеспечить постоянное поступление свежего воздуха в помещение. В противном случае споры осядут на другой поверхности в комнате или проникнут в легкие, что тоже не очень хорошо.
Использовать защиту. Обязательно работать в маске и перчатках, которые защитят вас снаружи и внутри
При контакте с химией страдают кожа и легкие в первую очередь – не забывайте об этих мерах предосторожности.
Оставить комнату. Желательно не пребывать в помещении после проведения процедуры хотя бы сутки
Комната обязательно должна проветриться, чтобы никому в ней не стало плохо, а споры полностью исчезли со всех поверхностей.
Если соблюдать все эти правила, то не только здоровье не пострадает, но еще и зачистка пройдет достаточно эффективно. В противном случае может произойти отравление или удушье ядовитыми веществами.
Профессиональные средства
В том случае, когда заражение настолько сильное, что вообще ничего не помогает, приходиться прибегать к средствам из магазина. Обязательно нужно читать показания к применению, а именно для какого рода плесени применяется то или иное средство
На каждой упаковке есть инструкция, которой тоже важно следовать для собственной безопасности и качественного очищения

Чаще всего используют следующие средства:
- Саво;
- Дали;
- Фонгифлюид;
- Стоп-плесень и др.
В магазине нужно точно описать источник заражение и общее состояние. Специалисты помогут подобрать наиболее действенный и подходящий вариант для каждого случая.
Виды черной плесени
Черная плесень — грибковые микроорганизмы, которые размножаются спорами, питаются омертвевшими органическими клетками. Обитают на стенах, мебели, карнизах, плинтусах. С виду плесень похожа на темные бархатистые пятна. Разрастается с огромной скоростью, в любых благоприятных местах.
К черной плесени относится несколько сотен штаммов грибков, большинство из которых считаются особенно опасными для здоровья:
- Аспергилл черный. Предпочитает влажную теплую среду. Особенно часто встречается на стенах в санузлах, ванных комнатах, в стиральных машинах, на подоконниках. Приводит к развитию аспергиллеза у людей и животных.
- Чёрная гниль. Любит селиться на подгнивших фруктах и овощах. Иногда разрастается на сырой древесине.
- Аспергилл дымящий. Поражает продукты питания, стены домов, квартир. Грибок опасен для людей, склонных к аллергии, заболеваниям бронхов.
- Пеницилл. Многоклеточный грибок, живущий рядом с человеком. Практически не наносит вреда здоровью.
У вас есть черная плесень в доме?
Нет
12.12%
Постоянно боремся
67.68%
Возможно, под отделкой
20.2%
Проголосовало: 99
Что произойдет, если вы съедите заплесневелую пищу?
Но что если вы не заметили, что ваше яблоко или хлеб заплесневели, прежде чем откусить большой кусок? Когда дело доходит до проглатывания плесени, нужно беспокоиться о потенциальных токсинах, которые могут скрываться внутри. Сама плесень скорее не будет проблемой. Но токсин, который она производит, вот в чем проблема.
Эти производимые плесенью токсины называются микотоксинами и включают семейство токсинов, называемых афлатоксинами. Которые связаны с раком печени. Микотоксины можно сравнить с ядовитым змеиным ядом. За исключением того, что его действие имеет более длительный срок.
Негативные эффекты микотоксинов не проявляются при однократном приеме внутрь. Вместо этого эти вредные эффекты со временем накапливаются в организме.
Таким образом, даже если вы чувствуете себя хорошо после того, как съели заплесневелый кусок пищи, микотоксины могут накапливаться в вашем теле.
Профилактика и перечень мероприятий по удалению плесени на стенах
Помимо разрушающего эффекта строительного материала, неэстетичного вида помещения, споры черной плесени, а вернее грибок аспергилл, попадая в организм человека, может вызвать аллергическую реакцию, приступ удушья или головную боль. Такие вредоносные образования на стенах могут поразить ЦНС, кожу, пищеварительную, дыхательную и даже половую систему, а это, в свою очередь, в совокупности с другими предрасполагающими факторами, например, на фоне иммунодефицита, может привести к смерти. В связи с этим, чтобы не допустить появление «невидимого врага», то есть предотвратить его появление или избавиться от черной плесени на стенах в доме навсегда, рекомендуется выполнять следующий перечень профилактических мероприятий:
- Систематически и постоянно проветривать все помещения в доме, особенно туалет и ванную комнату.
- Как можно чаще проводить уборку помещений.
- При расстановке крупногабаритной мебели в комнатах не ставить мебель плотно к стенам, чтобы избежать впоследствии конденсата на обеих поверхностях − самой благоприятной среде для обитания грибка.
- Не допускать повышения влажности в помещениях дома.

Медным купоросом рекомендуется в течение 1-2 месяцев обрабатывать пораженные плесенью участки
При невыполнении мер по профилактике плесени на поверхностях (стенах, потолке, углах и т.д.) бороться с плесенью можно следующими средствами:
- Формалин. Весьма ядовит, поэтому категорически запрещается допускать его попадание как на кожные покровы, так и на пищевые продукты. Его необходимо просто в небольшом количестве развести в воде и при помощи марлевого или ватного тампона смочить, а затем аккуратно удалить плесень с поверхности стен, потолка и т.д.
- Медный купорос. Менее опасный компонент, добавляемый в обычную воду, которой затем рекомендуется в течение 1-2 месяцев обрабатывать пораженные плесенью участки при помощи марлевой или кухонной тряпки.
- Антраценовое масло, а также эфирное масло монарды (известной, как бергамот дикий или мелисса), лаванды и чайного дерева. Эти редкие, но не менее эффективные средства также будут полезны в борьбе с плесенью, причем действие их достаточно продолжительно.
- Хлоросодержащие вещества, например, отбеливатель, которые можно приобрести в магазине и протереть ими пораженную поверхность.

Отбеливатель поможет бороться с черной плесенью





































